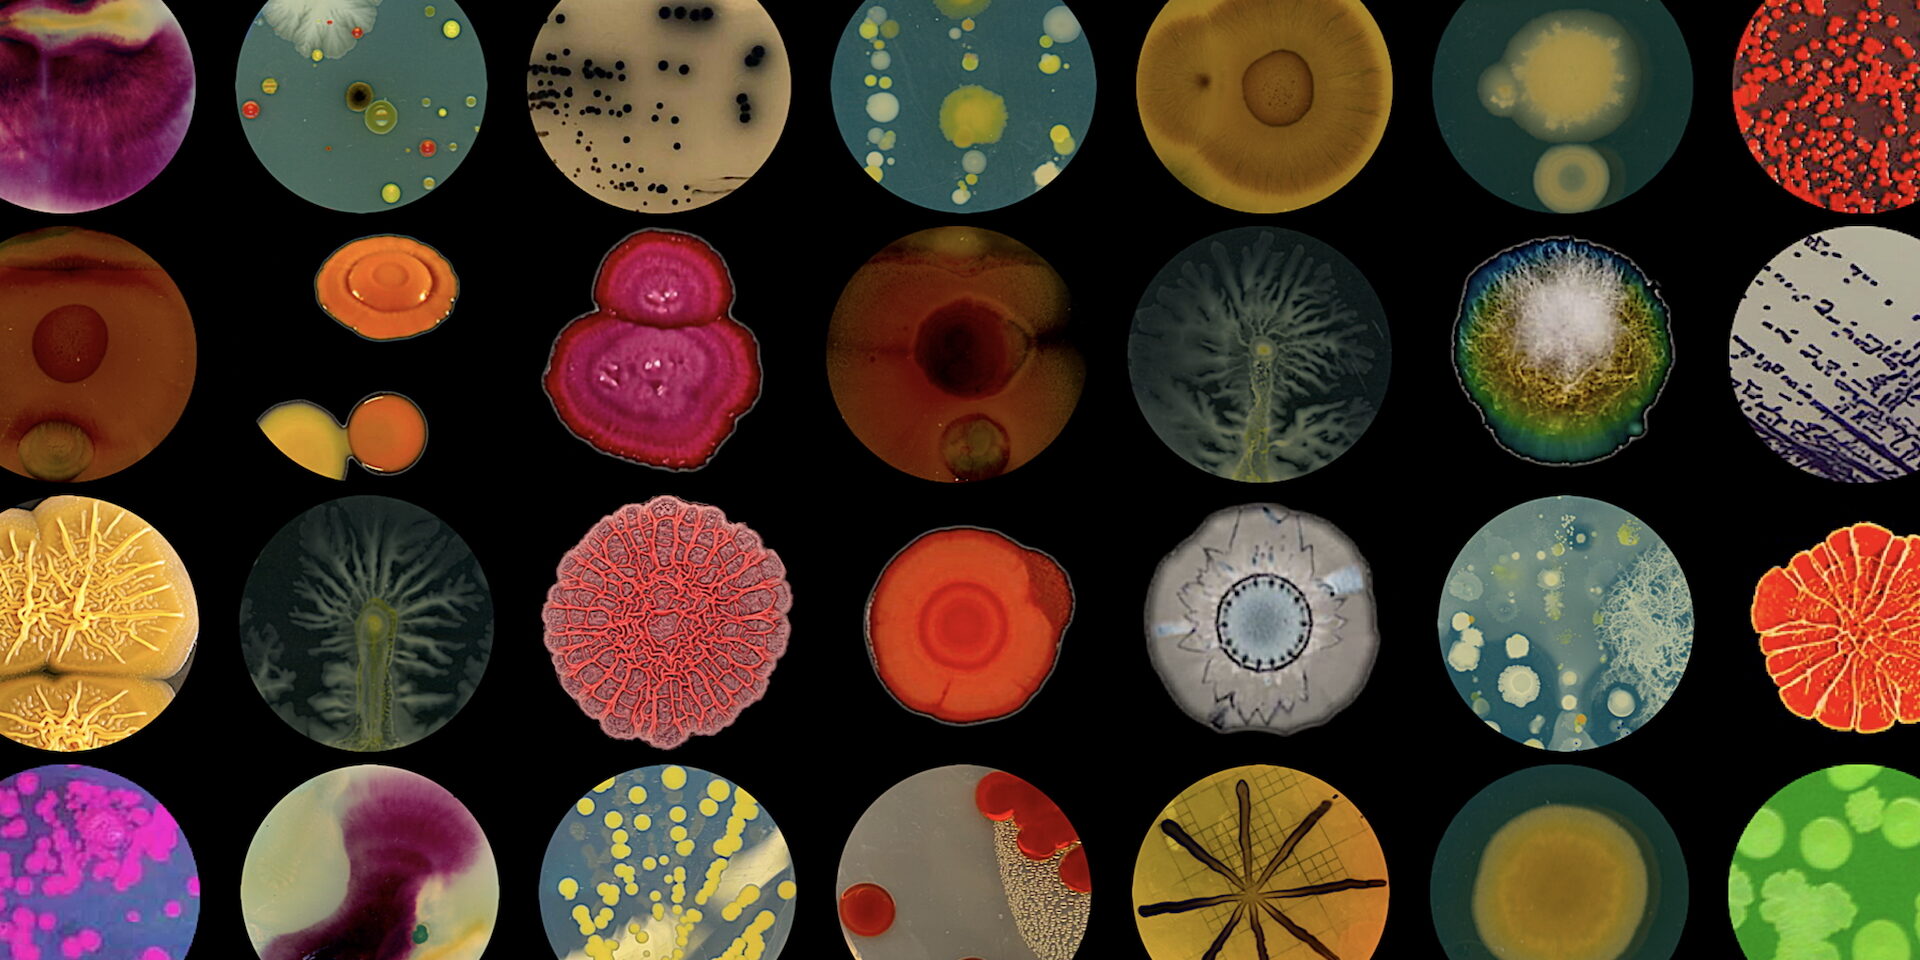
Scienza in Piazza: BIOTECNOLOGIE

SPAZIO ICGEB – Villaggio Trieste Città della Conoscenza
_
Insieme ai ricercatori e alle ricercatrici dell’ICGEB, scopriremo tre progetti Interreg che mettono la scienza al servizio della società: si tratta di azioni che migliorano la salute del suolo per sostenere la crescita delle piante, accelerano il trasferimento dei risultati scientifici verso le persone e promuovono la collaborazione internazionale per sviluppare nuove terapie innovative.
– il progetto CEDRIC rafforza la biodiversità di terreni che hanno perso fertilità, ripristinando la biodiversità microbiologica, fondamentale per la fertilità del suolo. Ispirandosi al successo del trapianto del microbioma umano, CEDRIC mira a trasferire, nei suoli poveri o sfruttati, i microbiomi delle radici di piante sane per migliorare la struttura del suolo, la densità dei nutrienti e i livelli di carbonio nel suolo;
– il progetto PROMOS promuove l’ecosistema biomedico italo-austriaco e la creazione di nuove PMI biomediche grazie a un percorso transfrontaliero di trasferimento tecnologico dal mondo accademico verso il mercato e la clinica. PROMOS vuole aumentare la capacità di capitalizzare i risultati scientifici, trasformandoli in prodotti commercialmente e socialmente utili.
– il progetto COHERENCE instaura un approccio collaborativo per sviluppare una terapia cellulare per le ferite difficili. Utilizzando l’esperienza dei singoli partner, il progetto avvierà un primo studio clinico di fattibilità e testerà una piattaforma online per aiutare medici e ricercatori a orientarsi nella regolamentazione nazionale ed europea delle terapie avanzate.
–
L’attività è rivolta a tutti, non è necessaria la prenotazione.